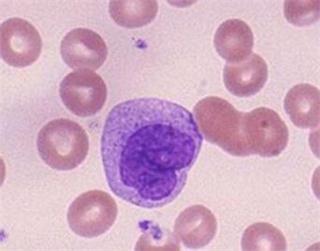
人外周血中各种血细胞成分密度,人外周血细胞计数

一、基本信息
细胞名称:Human PBMC(人外周血单个核细胞)
生长类型:悬浮细胞
培养基:90% RPMI1640+10% FBS
二、简介
人外周血单个核细胞分离自外周血。外周血单个核细胞( PBMC )即外周血中具有单个核的细胞,包括淋巴细胞和单核细胞。目前,主要的分离方法是密度梯度离心法,因为血液中各有形成分的比重存在差异,因此得以分离出不同的细胞。人外周血单个核细胞采用取外周血、通过密度梯度离心法制备而来,细胞总量约为5 x105cells/瓶;细胞纯度可达90%以上,且不含有HIV-1、HBV、HCV. 支原体、细菌、酵母和真菌等。
三、分离步骤
1、取新鲜抗凝 全血(EDTA、枸橼酸钠或肝素抗凝均可)或者去纤维蛋白血液,用等体积的全血及组织稀释液或者PBS稀释全血。
2、在离心管中加入适量分离液,将稀释后的血液平铺到分离液液面上方,注意保持两液面界面清晰。
3、室温,水平转子500~1000g,离心20~30min(血液的体积越大所需的离心力越大,离心时间越长,最佳的分离条件需摸索,离心转速最大不超过1200g)。
4、离心后将出现明显的分层:最上层是稀释的血浆层,中间是透明的分离液层,血浆与分离液之间的白膜层即为单个核细胞层,离心管底部是红细胞与粒细胞。
5、小心的吸取白膜层细 胞到15mL洁净的离心管中,10mL PBS或细胞洗涤液洗涤白膜层细胞。250g,离心10min。
6、弃上清,5mL的PBS或细胞清洗液重悬细胞,250g,离心10min。
7、重复步骤6
8、弃上清,细胞重悬备用。
四、人外周血单个核细胞的运输和保存
视天气状况和运输距离远近,公司与客户协商后选择下述方式中的一种进行。
1、1mL冻存细胞悬液装于1.8ml的冻存管中,置于装满干冰的泡沫保温盒中进行运输;收到细胞后请尽快解冻复苏细胞进行培养,如无法立刻进行复苏操作,冻存细胞可在-80℃的条件下保存1个月。
2、T-25培养瓶充满完全培养基后进行常温运输;收到细胞后请镜下观察细胞生长状态,如铺瓶率超过85%请立即进行传代操作,如悬浮的细胞较多,请将培养瓶至于培养箱中静置过夜以帮助未死亡的悬浮细胞能够再次贴壁。
中国微生物菌种查询网自设细胞系板块,是细胞株提供中心,专业提供代次低、周期短、活性好的细胞株。与国内外多家研制单位,生物医药,第三方检测机构,科研院所有着良好稳定的长期合作关系!欢迎广大客户来询!